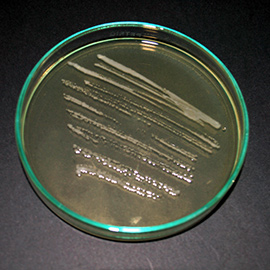

Presentación
El proyecto INLARVI tiene por objetivo iniciar esta red de manera práctica con un foco dirigido a despejar problemáticas de tres recursos de moluscos de gran interés comercial para Chile, y que han mostrado una alta complejidad para la obtención de juveniles.
Estos son el recurso loco (Concholepas concholepas) que se distribuye a lo largo del país y el recurso pulpo que se obtiene a lo largo del país desde dos especies muy diferentes, como son el pulpo del Norte o de los Changos (Octopus mimus) y el pulpo del sur o pulpo rojo Patagónico (Enteroctopus megalocyathus).